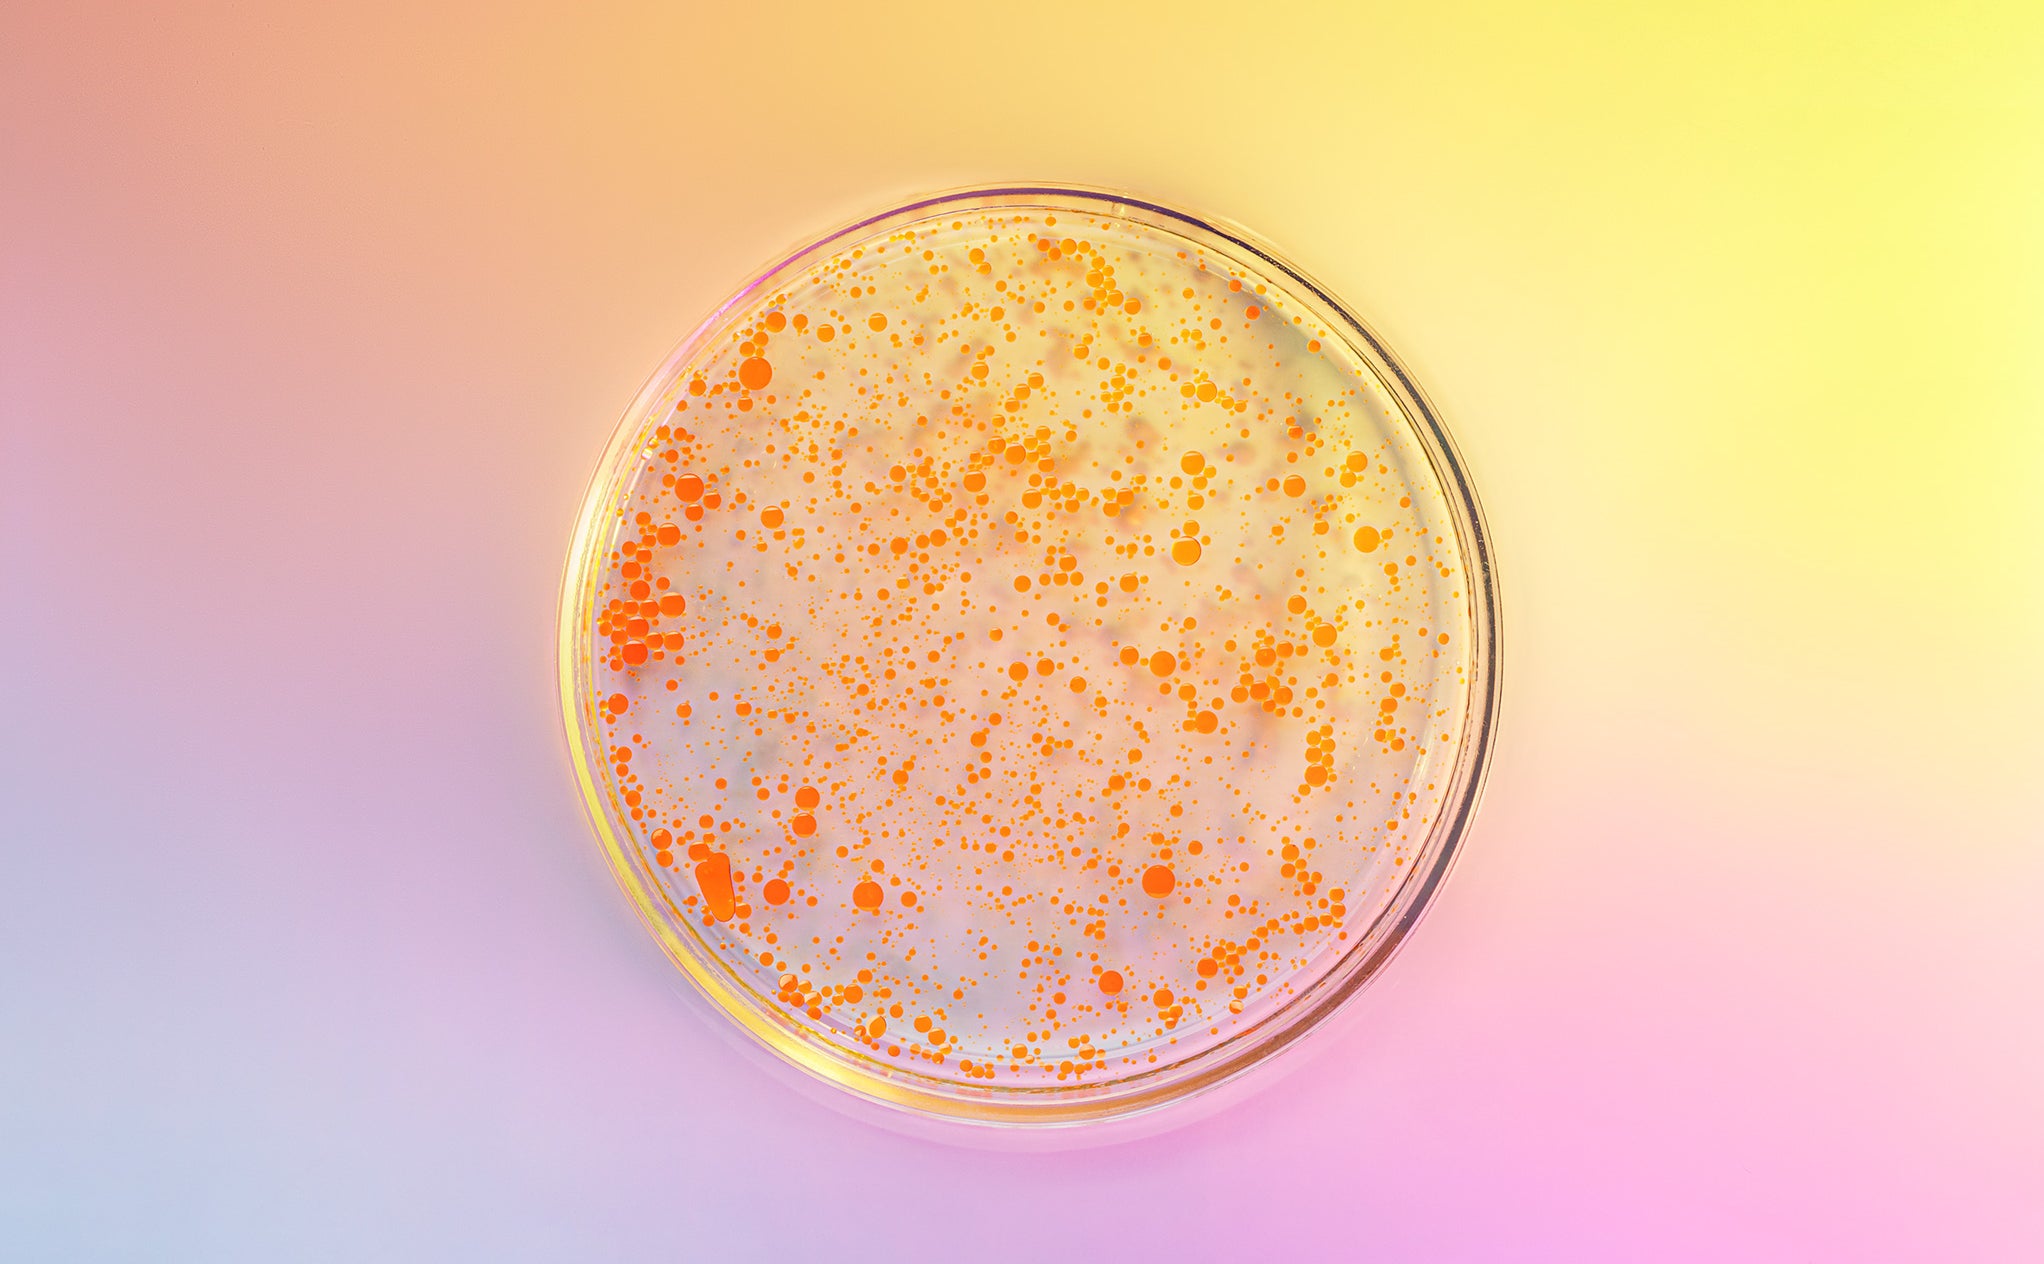
Petri dish showing bacterial growth used for testing disinfectant efficacy and hygiene standards

Arxada is a global industry trailblazer in innovative solutions that protect our world.
We develop and register disinfectants for professional markets, including healthcare, food and beverage and industrial and institutional sectors.
Our valued business partners may market these solutions under their own brand, with Arxada support covering key aspects of the BPR (including requirements under the National Transitional Schemes for EU Member States) and the MDR.
This partnership model can contribute to a more efficient path towards commercialization of innovative formulations.

For more information or to stay up-to-date with our news, please contact us or sign up to our e-Newsletter.